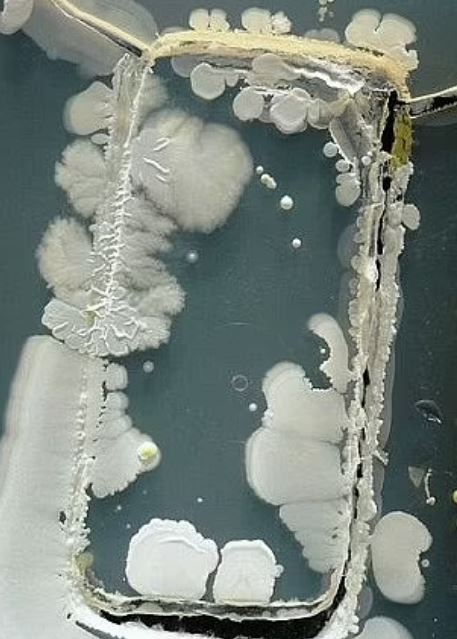
拼盘∕爱在床上滑手机者三思 英研究警告恐接触“蟑螂身上细菌”

爱在床上滑手机者三思 英研究警告恐接触“蟑螂身上细菌”



(伦敦16日综合电)许多人睡前都可能有这习:躺在床上滑手机,这除了容易令腰背部紧绷及颈部疼痛,伤眼睛之外,如今有科学家警告说,在床上使用手机可能比原先想像带来更多害处,智能手机上可能带有大量细菌,包括蟑螂与其粪便经常发现的绿脓杆菌(pseudomonas aeruginosa),对于免疫力低下族群而言,恐怕引起感染、红疹、痘痘、甚至是败血症等。
综合《每日邮报》和ETToday新闻云等媒体报道,一个人每天平均触摸手机2617次,这种3C设备很快就变得不太卫生,似乎不足为奇。
ADVERTISEMENT
而英国寝具品牌“MattressNextDay”也赞助一项研究,试图了解智能手机上,究竟藏有哪些病菌。
研究人员从10支智能手机与10支智能手表上采样,并且把这些病菌放入实验室生长。结果发现,智能手机可能是最脏的3C产品,病菌量比先前居冠的电视遥控器更多。
此外,手机上最常发现的细菌就是绿脓杆菌,尽管在大多数情况下无害,对于免疫力低下族群,却可能导致更严重的并发症,例如眼睛感染、红疹、痘痘、腹泻,甚至是肺炎、尿道感染、败血症等。

另一项针对575名成人的调查发现,高达74%受试者睡觉时,会把手机放在头部附近,或者枕头底下。科学家警告说,这可能会让人们接触手机上有害细菌。
更糟的是,铜绿假单胞菌在床上潮湿、温暖的气候中很容易大量繁殖。
MattressNextDay首席执行员希利表示:“记住,你的床应该是休息之处,而不是潜在有害细菌的培养皿。”
对此,专家建议定期使用酒精清洁手机,并且减少手机接触脸部的机会。
ADVERTISEMENT
热门新闻
百格视频
ADVERTISEMENT
